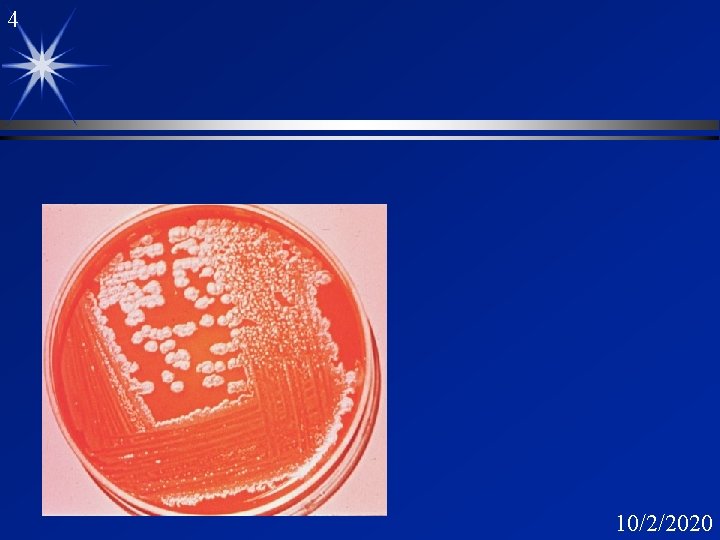
4 10/2/2020

1 Aerobic Endospore formers Bacillus Filename Bacillus ppt

1 Aerobic Endospore formers Bacillus Filename: Bacillus. ppt 10/2/2020

2 Epidemiology of Anthrax ä Disease/bacterial factors ä Transmission ä Who is at risk ä Geography/ season ä Incidence ä Modes of control 10/2/2020

3 Bacillus ä Gram positive ä Rod ä Spore formers ä Obligate aerobe 10/2/2020
4 10/2/2020

5 B. anthracis colony ä Medusa head 10/2/2020

6 10/2/2020

7 10/2/2020

8 Bacillus Spore 10/2/2020

9 Bacillus pathogens ä B. anthracis ä B. subtilis ä ä ä Foulbrood fatal disease of bees eye infections B. cereus ä ä B. alvei anthrax ä ä ä 2 forms offood poisoning Bacillus spp ä wounds, chronic ulcers, dust and soil 10/2/2020

10 Anthrax ä Mainly cattle, sheep, goats, horses ä Man infected by contact with diseased products ä Human transmission possible ä Outbreak in Gambia 10/2/2020

11 Anthrax: Incidence ä Humans incidence dropping steadily 100, 000 globally /year ä 1 -2 /year North America ä ä Endemic in animals in some states ä California, Louisiana, Mississippi, Arkansas, Texas, Dakota, Nebraska 10/2/2020

12 10/2/2020

13 10/2/2020

14 Forms of Anthrax ä Cutaneous ä 95% of human cases ä Intestinal ä common in cattle ä grazing ä Pulmonary ä now rare 10/2/2020

15 Anthrax: Wool sorter’s Disease 10/2/2020

16 Stevadore’s Disease 10/2/2020

17 Anthrax: Eschar ä Appears on exposed parts of body “Hide sorters disease” or “Stevadores 10/2/2020

18 Anthrax: Eschar ä spore germinates at site of entry ä black, malignant ä painless ä May heal spontaneously ä septicemia ä 20% mortality 10/2/2020

19 Evolution of an Anthrax Eschar Day 0 Day 6 Day 0 10/2/2020

20 Evolution of an Eschar Day 10 Day 15 10/2/2020

21 Pulmonary Anthrax ä Now rare ä mortality approaches 10% ä “Wool Sorters Disease” industrial mills 19 th century ä Pneumonia ä ä survives phagocytosis ä lymph nodes ä septicemia 10/2/2020

22 Anthrax: Pathogenesis ä Capsules antiphagocytic ä protein capsule ä ä Toxin ä Exotoxin ä p. H 7. 4, stabilized by serum & bicarbonate ä 3 sub components 10/2/2020

23 Anthrax toxin ä Edema factor (EF) ä 88. 9 Kda calmodulin dependent ä adenylate cyclase ä Lethal factor (LF) ä 90. 2 Kda ä zinc metalloprotease EF + PA = edema LF + PA = necrosis ä Protective antigen (PA) ä 82. 7 Kda ä 20 KDa fragment hyrdolyzed 10/2/2020

24 Action of Anthrax Toxin 10/2/2020

25 10/2/2020

26 The End 10/2/2020

27 Bacillus cereus Food Poisoning 10/2/2020

28 10/2/2020
- Slides: 28